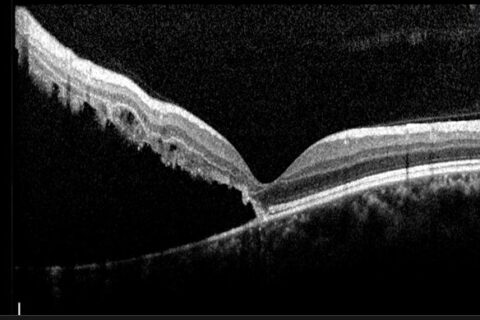
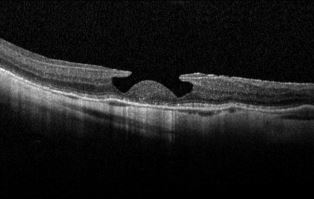

Αποκόλληση Αμφιβληστροειδούς on/off
Η προσβολή της ωχράς κηλίδας σε οφθαλμούς με αποκόλληση αμφιβληστροειδούς αποτελεί δυσμενή προγνωστικό παράγοντα για τη μετεγχειρητική λειτουργική αποκατάσταση ως προς την οπτική οξύτητα και όχι μόνο. Ωστόσο δεν πρέπει να παραβλέπεται το γεγονός πως η χρονική διάρκεια παραμονής υποαμφιβληστροειδικού υγρού στην περιοχή της ωχράς έχει καθοριστική σημασία, καθώς αποκατάσταση εντός 72 ωρών έχει αποδειχθεί…